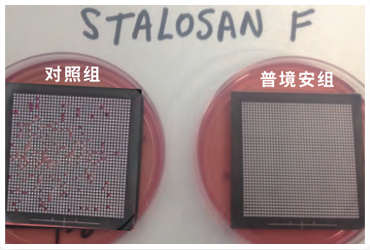

01 PART ONE ——————
想复养,电子游艺网站 洗消不彻底可不行
据相关报道指出:截至目前,还没有一个批准上市销售可防控非瘟的商品化疫苗。行业知情人称:我国发生非瘟疫情以来,各研究单位积极开展非瘟防控技术的研究,其工作进展不一,进度最快的也还处于临床前研究和转基因生物安全评价阶段,尚未向农业农村部提出开展临床试验申请。非洲猪瘟病毒威力强大,该疫情防控形势依然复杂严峻!
非洲猪瘟促使大量生猪被扑杀的背后,生猪复养已是大势所需。复养是一项基于生物安全措施的系统工程,涉及条件保障、饲养管理、饲料营养、环境控制、疫病防控等。电子游艺网站 复养需要经过大量细致缜密的准备工作,包括电子游艺网站 生物安全评估、电子游艺网站 全面洗消和评估、硬件设备升级改造等等。而电子游艺网站 生物安全做得好不好,洗消是否彻底,关乎着电子游艺网站 生死存亡。